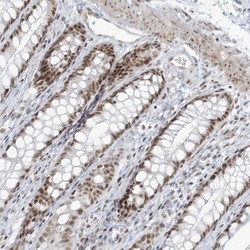

Antibody data
- Antibody Data
- Antigen structure
- References [0]
- Comments [0]
- Validations
- Western blot [1]
- Immunohistochemistry [1]
Submit
Validation data
Reference
Comment
Report error
- Product number
- NBP1-85911 - Provider product page

- Provider
- Novus Biologicals
- Proper citation
- Novus Cat#NBP1-85911, RRID:AB_11041422
- Product name
- Rabbit Polyclonal ZNF787 Antibody
- Antibody type
- Polyclonal
- Description
- Immunogen affinity purified. Specificity of human ZNF787 antibody verified on a Protein Array containing target protein plus 383 other non-specific proteins.
- Reactivity
- Human
- Host
- Rabbit
- Isotype
- IgG
- Vial size
- 0.1 ml
- Storage
- Store at 4C short term. Aliquot and store at -20C long term. Avoid freeze-thaw cycles.
No comments: Submit comment
Supportive validation
- Submitted by
- Novus Biologicals (provider)
- Main image

- Experimental details
- Western Blot: ZNF787 Antibody [NBP1-85911] - Lane 1: Marker [kDa] 230, 130, 95, 72, 56, 36, 28, 17, 11. Lane 2: Human cell line RT-4. Lane 3: Human cell line U-251MG sp
Supportive validation
- Submitted by
- Novus Biologicals (provider)
- Main image
- Experimental details
- Immunohistochemistry-Paraffin: ZNF787 Antibody [NBP1-85911] - Staining of human rectum shows moderate nuclear positivity in glandular cells.